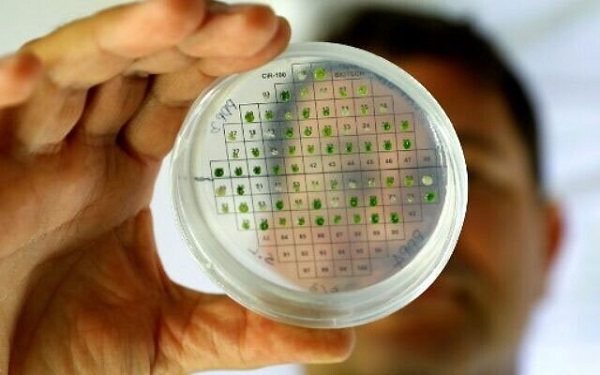

Danh sách bài viết theo Tags

Liệu trí tuệ nhân tạo có phải phát minh cuối cùng của con người?
Thứ sáu, 01/11/2024
Về mặt kỹ thuật, con người có thể tiếp thu bất kỳ kiến thức nào. Chúng ta giỏi ở nhiều kỹ năng và làm được những nhiệm vụ rất khác nhau, từ chơi cờ vua đến viết hoặc giải các câu đố khoa học. Một số người trong chúng ta là chuyên gia trong một số lĩnh vực và là người...
Hóa ra những phát minh công nghệ này là do "tai nạn"!
Rất nhiều đồ đạc xung quanh chúng ta được phát minh từ những "tai nạn" trong nghiên cứu.
Thứ hai, 14/11/2022
Ngắm loạt phát minh độc đáo, kỳ lạ các startup công nghệ khoe ngay đầu năm 2022
Bàn mát-xa robot, mèo robot âu yếm, bóng đèn theo dõi sức khỏe... là những "phát minh" độc đáo, kỳ lạ, gây chú ý tại Triển lãm Điện tử Tiêu dùng 2022 (CES)...
Thứ tư, 27/04/2022
Nhà phát minh Trần Ngọc Phúc chế tạo khẩu trang làm mát phổi
Khẩu trang có màng lọc diệt virus và kết nối với thiết bị lọc khí, không gây khó thở, thuận tiện cho hoạt động trao đổi khí trong phổi.
Thứ hai, 26/07/2021
Israel phát minh thiết bị thử máu không cần kim tiêm lấy mẫu
Thay vì dùng kim tiêm để lấy máu như thông thường, y tá chỉ cần dùng một thiết bị quét cặp mắt của người bệnh trong vài giây và cho kết quả chính xác...
Thứ sáu, 23/07/2021
Phát minh thiết bị công nghệ hỗ trợ thị giác
Thiết bị là sự kết hợp giữa kính chơi game và kính cận, nó tạo ra hình ảnh 3D mà văn bản, đồ họa và video có thể được phủ lên trên hình ảnh thế...
Thứ sáu, 23/07/2021
Phát minh vật liệu giúp sản xuất điện trong cơ thể người
Ngày 6/7, các nhà khoa học thuộc trường Đại học Tel Aviv (Israel) đã công bố một loại vật liệu nano có thể “bắt” các bộ phận trong cơ thể sản xuất ra...
Thứ tư, 21/07/2021
Phát minh thành công loại kính tự điều chỉnh ánh sáng
Một công ty công nghệ kỳ vọng phát minh các tấm kính nhà cao tầng thông minh sẽ thay đổi cách mọi người sống và làm việc trong thời gian tới, đồng thời...
Thứ năm, 25/03/2021
Phát minh vải điện tử có thể được sử dụng làm màn hình hiển thị
Màn hình dẻo là một hướng quan trọng cho sự phát triển của màn hình hiển thị thiết bị điện tử.
Thứ tư, 31/03/2021
Những phát minh hữu ích
Một công ty công nghệ kỳ vọng phát minh các tấm kính nhà cao tầng thông minh sẽ thay đổi cách mọi người sống và làm việc trong thời gian tới, đồng thời...
Thứ tư, 24/03/2021

.jpg)



















.jpg)























.png)



.jpg)






















